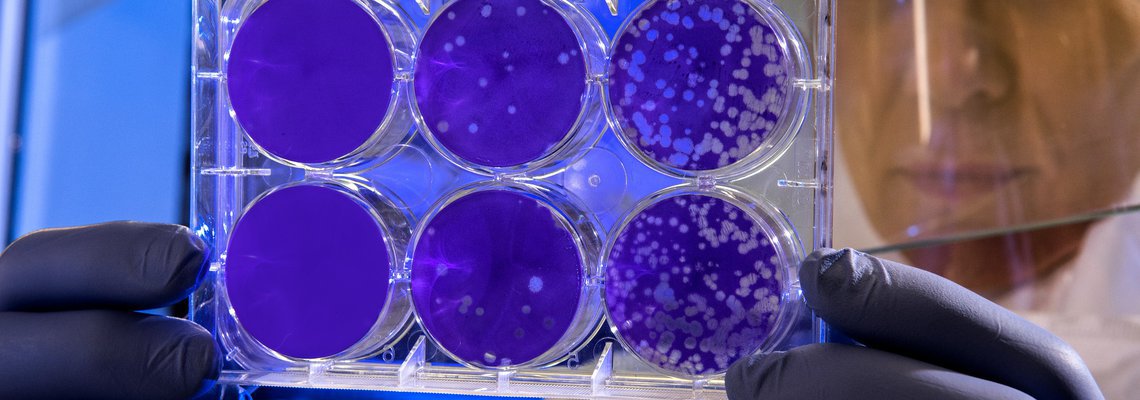
Entrepreneurs from Africa and MENA Offering Their Solutions to Fight COVID-19

AFRICA • HEALTHCARE
Saad Zgaoui
APRIL 13, 2020
After the outbreak of COVID-19, more than ever we need efficient tech solutions. With millions of people being in quarantine around the world, it is natural that everyone is looking for online alternatives for learning and growth or for medical consultations without having to leave their home. Multiple companies around the world have brought solutions to fight the global pandemic, such as Ejenta that extended its platform for COVID-19, enabling health providers to rapidly scale scarce healthcare resources through self-screening, remote monitoring and virtual care. Ejenta is currently working with the largest health provider in the US, following up with frontline doctors and nurses. Lazarus has also launched CATCH: a simple and free assessment for COVID-19 that gives patients an instant recommendation based on the CDC’s guidelines and links the data with medical providers that can then track patients’ cases, predict surges, and make sure that they get appropriate attention and care.

We share with our network of over 20,000 startups a significant mission of impacting people’s lives in emerging markets through tech and entrepreneurship. That is why in these hard times where the virus has spread to dozens of countries in Africa within weeks, we are very glad to see a lot of amazing entrepreneurs acting positively in their societies and contributing to the well-being of the global community.
We checked out some of the startups in our network in the Middle East and Africa, who are currently working to find and provide solutions for challenges brought by this global pandemic. They work across different industries, offering their tech solution to their people and their governments to make it easier for everyone to stay at home and stay safe. Here are some of the examples we found:
REMA, the local winner of Seedstars Abidjan 2018, is a mobile application for remote medical collaboration developed for doctors in Africa. Its main mission is to connect doctors in the continent and allow them to exchange best practices and collaborate in real-time to make better medical decisions about patients’ diagnosis. After the breakout of the COVID-19 pandemic, they have made access to their institutional medical communication system entirely free for health ministries, particularly those in West African countries. This will facilitate the coordination, information and training in real-time and without physical contact of health professionals during the outbreak.

7keema, Seedstars World Cairo 2018 winners
7keema, an Egyptian home nursing startup and winner of the Seedstars World Cairo 2018, has partnered with the top private sector leaders and a number of healthcare professionals in Egypt and abroad to launch the “One4All” initiative to collectively provide their services to the nation during this pandemic. As an on-demand nursing service app, 7keema is providing free, online counselling services, including an algorithm-powered chatbot that assesses symptoms of the user to determine whether they are at risk of having COVID-19 and need testing, as well as triage sessions to help with the treatment of different cases.
In Morocco, the government recommends using Dabadoc. This new video consulting service is as an alternative to physical consultation and it allows doctors to give online consultations using a video call with their patients. This way, patients don’t need to visit the hospital and can stay safely at home.. The startup was created in 2014 and offers booking doctors’ appointments online. It became one of the three winners of Seedstars World Casablanca in the same year. They have adjusted their services to adapt to the current situation with the COVID-19 outbreak.

Medical video consulting as alternatives
When it comes to alternative solutions for learning and education, Startups such as Kinedu, Lamsa and Afini have provided free access to their platforms for one month in the United Arab Emirates. They also offered discounted rates for all families in the UAE if they wish to continue using their premium services.
Lamsa is an Emirati startup that provides quality educational and entertainment content for kids aged 2-8 to support their educational curriculum and help them discover their talents.
We are very happy to see entrepreneurs in Africa and the Middle East taking the lead in their societies to bring effective solutions in a time of hardships, contributing to making an impact in people's lives and encouraging them to continue their lives from home. Hats off!